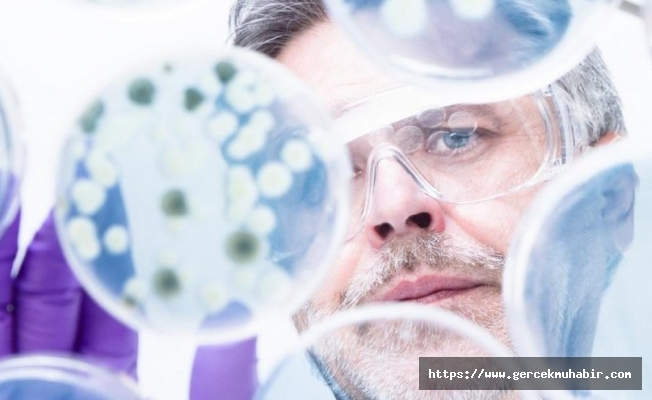

23. Ulusal Kanser Kongresi; Türk Pediartik Onkoloji Grubu Derneği, Türk Tıbbi Onkoloji Derneği ve Türk Radyasyon Onkolojisi Derneği (TROD) iş birliğiyle Antalya'da gerçekleştirildi. Kongrede konuşan TROD başkanı Prof. Dr. Yavuz Anacak ve derneğin eş başkanı Prof. Dr. Esra Kaytan Sağlam proton terapisiyle ilgili önemli bilgiler verdi.
İYİ SONUÇ ALINIYOR
“Dünya Sağlık Örgütü verilerine göre Türkiye'de her yıl 4 bin 700 çocuk kanser tanısı alıyor ve yaklaşık bin 400 çocuğu kaybediyoruz” diyen Prof. Dr. Yavuz Anacak; şöyle konuştu: “Kanser hastası çocukların yüzde 70-80'ini kurtarabiliyoruz. Ancak tedaviden sonra, çocuklarda uzun dönemde tedaviye bağlı kalıcı yan etkiler; her türlü gelişme geriliği, hormonal, ortopedik bozukluklar ve tedaviye bağlı ikinci kanserler ortaya çıkabiliyor. İşte bu etkilerin azaltılmasında proton terapisi önemli bir fırsat.”
Prof. Dr. Esra Kaykan Sağlam da proton tedavisiyle ilgili şunları söyledi:

YEPYENİ BİR YÖNTEM
“Proton terapisi radyoterapinin teknolojide geldiği son nokta… Biz proton terapileri özellikle çocukluk çağı kanserlerinde, kafa tabanı yerleşimli tümörlerde, orbita yerleşimli tümörlerde kullanmak istiyoruz. Tabii bunun dışında pek çok tümör türünde de küratif amaçlı kullanılabilir. Proton tedavisinin pediatrik tümörlerde, normal dokularla çok yakın ilişkisi olan etkin olduğunu gördük. Bizi en çok heyecanlandıran da bu oldu.”
ADIM ATMALIYIZ
“Bugün Türkiye'de proton tedavi merkezi kurmaya karar verdiğimizde 5 seneye ihtiyacımız var, bu nedenle acilen adım atmamız gerekiyor. Türk Radyasyon Onkolojisi Derneği olarak en önemli vurgumuz bu merkezi, özellikle pediatrik onkolojide ve radyoterapi teknolojisinde ehil öğretim üyelerinin ve kalifiye insan gücünün olduğu yerlerde kurmak. Çünkü radyasyon onkolojisi teknolojiyi iyi kullanan bir branş ama insan gücü faktörünü yok saydığımız an teknolojiyi çöpe atmış oluruz. Çünkü burada milyon dolarlık bir yatırımdan bahsediyoruz. Türkiye'de tek ya da iki merkez yeterli olur. Türkiye ne yazık ki şu an ABD ve Avrupa'ya proton tedavisi için hasta gönderiyor.”
(sözcü)